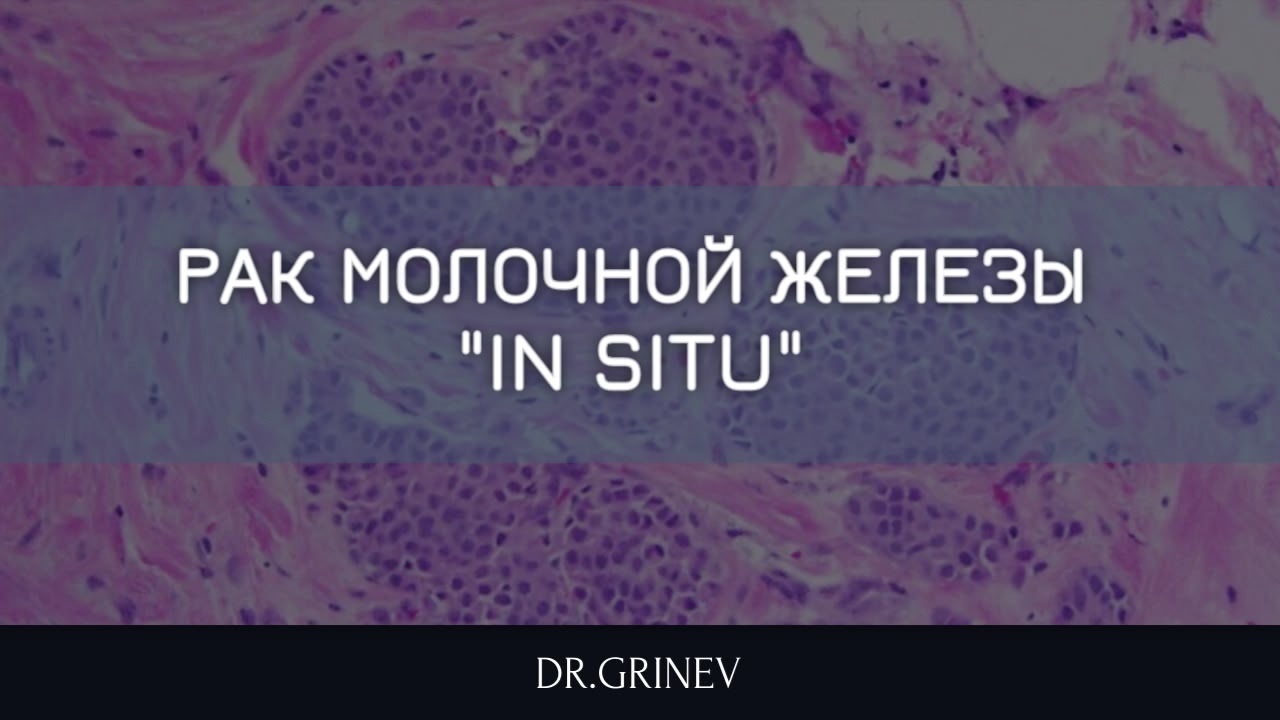

Рак in situ (что означает «на месте») представляет собой доброкачественное заболевание с неясным потенциалом озлокачествления. На этом этапе клетки начинают изменяться и делиться, однако еще не проникают в близлежащие ткани и не прорастают в сосуды.
Выявить рак in situ сложно, поскольку такие опухоли зачастую не видны на УЗИ, определяются в виде скопления микрокальцинатов на Маммографии и обычно не вызывают никаких симптомов.
Рак in situ молочной железы считается неинвазивной формой заболевания и имеет 0 стадию, также известную как «предрак». В международной классификации болезней считается доброкачественным заболеванием Хотя эта патология не представляет непосредственной угрозы для жизни женщины, существует высокий риск ее преобразования в инвазивную форму рака.
Рак классифицируется на инвазивный и неинвазивный. В случае инвазивного рака злокачественные клетки распространяются на здоровые ткани, тогда как неинвазивный рак (in situ) остается «на месте» и не затрагивает соседние области.
Опухоль образуется в молочных протоках, где клетки создают злокачественное новообразование, оставаясь в пределах протока и не нарушая функции здоровых тканей. Это состояние также обозначается как DCIS в международной терминологии.
Другим вариантом рака in situ является дольковая карцинома молочной железы (LCIS), при которой образуются онкологические клетки в дольках молочной железы, и они редко проникают за пределы дольки или в другие органы.
Лечение
Подход к лечению рака молочной железы in situ зависит от расположения новообразования, его размеров, количества пораженных участков, общего состояния здоровья пациентки и наличия факторов риска.
В случае дольковой карциномы чаще всего не требуется оперативное вмешательство. Пациентка должна регулярно проходить осмотры для динамического наблюдения за состоянием. Если речь идет о гормон-рецептор-положительной карциноме, рекомендуется назначение гормональных препаратов, которые блокируют взаимодействие раковых клеток с женскими половыми гормонами, что позволяет замедлить развитие опухоли.
При протоковой карциноме обычно предлагают хирургическое лечение, которое может включать удаление лишь пораженной области или полную мастэктомию.
️Такая операция существенно снижает риск последующего развития инвазивного рака.
#рмж #ракгруди #ракinsitu #insitu #ракмолочнойжелезы
Выявить рак in situ сложно, поскольку такие опухоли зачастую не видны на УЗИ, определяются в виде скопления микрокальцинатов на Маммографии и обычно не вызывают никаких симптомов.
Рак in situ молочной железы считается неинвазивной формой заболевания и имеет 0 стадию, также известную как «предрак». В международной классификации болезней считается доброкачественным заболеванием Хотя эта патология не представляет непосредственной угрозы для жизни женщины, существует высокий риск ее преобразования в инвазивную форму рака.
Рак классифицируется на инвазивный и неинвазивный. В случае инвазивного рака злокачественные клетки распространяются на здоровые ткани, тогда как неинвазивный рак (in situ) остается «на месте» и не затрагивает соседние области.
Опухоль образуется в молочных протоках, где клетки создают злокачественное новообразование, оставаясь в пределах протока и не нарушая функции здоровых тканей. Это состояние также обозначается как DCIS в международной терминологии.
Другим вариантом рака in situ является дольковая карцинома молочной железы (LCIS), при которой образуются онкологические клетки в дольках молочной железы, и они редко проникают за пределы дольки или в другие органы.
Лечение
Подход к лечению рака молочной железы in situ зависит от расположения новообразования, его размеров, количества пораженных участков, общего состояния здоровья пациентки и наличия факторов риска.
В случае дольковой карциномы чаще всего не требуется оперативное вмешательство. Пациентка должна регулярно проходить осмотры для динамического наблюдения за состоянием. Если речь идет о гормон-рецептор-положительной карциноме, рекомендуется назначение гормональных препаратов, которые блокируют взаимодействие раковых клеток с женскими половыми гормонами, что позволяет замедлить развитие опухоли.
При протоковой карциноме обычно предлагают хирургическое лечение, которое может включать удаление лишь пораженной области или полную мастэктомию.
️Такая операция существенно снижает риск последующего развития инвазивного рака.
#рмж #ракгруди #ракinsitu #insitu #ракмолочнойжелезы